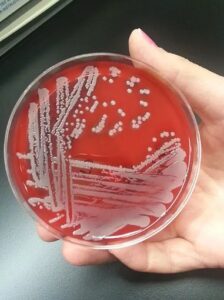
terapia

Bactéria Staphylococcus aureus
Em um cenário onde o desenvolvimento de novos antibióticos se torna cada vez mais desafiador, cientistas buscam alternativas para potencializar a eficácia dos tratamentos existentes. Uma abordagem inovadora, liderada pelo físico e engenheiro de materiais Vanderlei Salvador Bagnato, demonstrou resultados promissores ao enfraquecer bactérias resistentes, tornando-as mais suscetíveis aos antibióticos disponíveis.
A pesquisa

A pesquisa, divulgada na renomada revista Proceedings of the National Academy of Sciences (PNAS), revelou que a técnica de inativação fotodinâmica (PDI) pode alterar a sensibilidade das bactérias aos antibióticos. O estudo focou na Staphylococcus aureus, responsável por infecções que variam de problemas cutâneos a pneumonia, e constatou que após cinco ciclos de PDI, a resistência das bactérias foi significativamente reduzida.
Leia também
O gigante das águas que promete transformar o turismo sustentável no coração da Amazônia
A nova edição da Revista Amazônia traz ciência, soluções e esperança para o futuro do planeta
Julho registra menor área queimada em sete anos, mas especialistas alertam para riscos no CerradoA técnica de PDI consiste na utilização de luz e um fotossensibilizador – no caso, a curcumina – que, ao serem ativados pela luz, geram reações de oxidação capazes de destruir os microrganismos ou diminuir sua resistência. Os pesquisadores observaram que, em particular, a gentamicina mostrou-se mais efetiva após o tratamento fotodinâmico, embora a amoxicilina e a eritromicina também tenham apresentado bons resultados.
Centro de Pesquisa em Óptica e Fotônica
O professor Bagnato, coordenador do Centro de Pesquisa em Óptica e Fotônica (CePOF) e vinculado ao Instituto de Física de São Carlos (IFSC) da Universidade de São Paulo (USP), explicou que o processo fotodinâmico pode não eliminar completamente a bactéria, mas é capaz de destruir mecanismos de resistência, abrindo caminho para um “choque oxidativo” que as torna vulneráveis novamente aos antibióticos.
Este avanço surge em um momento crítico, com a Organização Mundial da Saúde (OMS) classificando a resistência antimicrobiana como uma das dez maiores ameaças à saúde pública global. A resistência ocorre quando microrganismos se adaptam e sobrevivem ao tratamento com antimicrobianos, incluindo antibióticos e antivirais. A OMS estima que infecções por bactérias resistentes causam aproximadamente 1,2 milhão de mortes anualmente, com um impacto econômico que pode alcançar US$ 100 trilhões até 2050.
O trabalho de Bagnato e sua equipe representa uma esperança na luta contra a resistência bacteriana, especialmente em casos de pneumonia resistente, uma das principais causas de morte em unidades de tratamento intensivo. Com a perspectiva de novas publicações e técnicas aplicadas diretamente no pulmão, a pesquisa avança para combater essa ameaça crescente à saúde humana.
Enquanto Bagnato expande suas pesquisas na Universidade Texas A&M, nos Estados Unidos, seu legado continua a influenciar os estudos no Brasil, prometendo contribuições significativas para a medicina e a saúde pública mundial.
Nunca perca uma notícia da AmazôniaControle o que você vê no Google
O Google lançou as Fontes Preferenciais: escolha os veículos que aparecem com prioridade. Adicione a Revista Amazônia e garanta cobertura exclusiva sempre em destaque.
Adicionar Revista Amazônia como Fonte Preferencial1. Pesquise qualquer assunto no Google
2. Toque no ⭐ ao lado de "Principais Notícias"
3. Busque Revista Amazônia e marque a caixa — pronto!


















Você precisa fazer login para comentar.